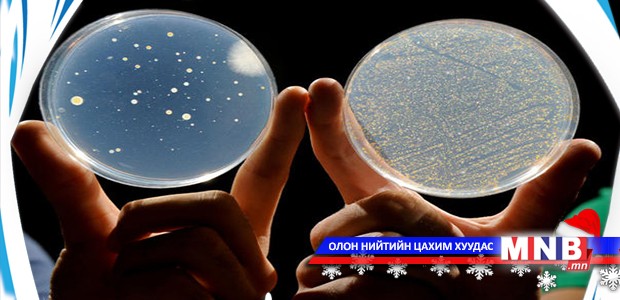

Өнөөдөр Монгол орны бичил биетний судалгааны өнөөгийн нөхцөл байдал, цаашдын хөгжлийн чиг хандлагыг тодорхойлох зорилгоор эрдэм шинжилгээний хурал зохион байгуулж байна. ШУА-ийн Биологийн хүрээлэнгээс санаачилсан "Монгол орны бичил биетэн-2014” хурлаар, Монголын Байгаль орчинд амьдарч байгаа бичил биетэнг судлах, цаашлаад тухайн судалгааны ажлыг бодит амьдралд нэвтрүүлэх шаардлагатай зэрэг асуудлыг хөндөн ярилцсан юм. Үргэлжлүүлэн “Хурд” агентлагийн сэтгүүлч Т.Батчимэг мэдээлнэ.
| Бичил биетний судалгааны хөгжлийг тодорхойлох хурал болж байна | ||
| Үзсэн: 1131 | Mongolian National Broadcaster |


 Үндэсний телевиз
Үндэсний телевиз






















































































































 Лханаагийн Мөнхтөр
Лханаагийн Мөнхтөр

 Р.Слава
Р.Слава

 Б.Цоожчулуунцэцэг
Б.Цоожчулуунцэцэг





Сэтгэгдэл бичих:
АНХААРУУЛГА: Уншигчдын бичсэн сэтгэгдэлд MNB.mn хариуцлага хүлээхгүй болно. ТА сэтгэгдэл бичихдээ хууль зүйн болон ёс суртахууны хэм хэмжээг хүндэтгэнэ үү. Хэм хэмжээг зөрчсөн сэтгэгдэлийг админ устгах эрхтэй. Сэтгэгдэлтэй холбоотой санал гомдолыг 70127055 утсаар хүлээн авна.